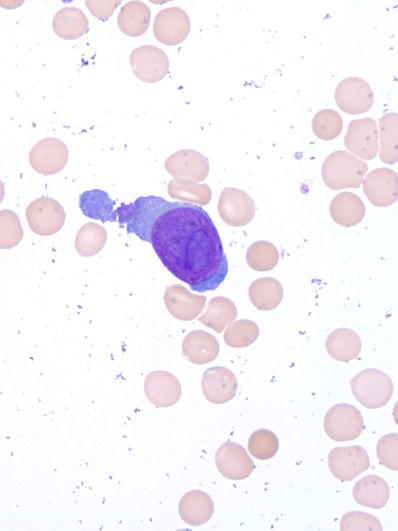

top of page
2. Peripheral Blood
Red blood cells
Red blood cell infections
Neutrophils
Neutrophils in infectious processes
Eosinophils
Basophils
Monocytes
Lymphocytes
Blasts
Chronic myeloid leukemia
Chronic lymphoproliferative disoders/lymphomas
Plasma cell myeloma
bottom of page